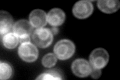
YDR508C
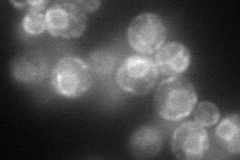
YDR508C
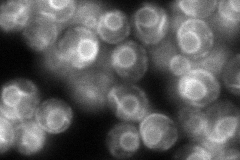
YDR508C
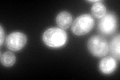
YDR508C
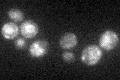
YDR508C

View description
High-affinity glutamine permease, also transports Leu, Ser, Thr, Cys, Met and Asn; expression is fully dependent on Grr1p and modulated by the Ssy1p-Ptr3p-Ssy5p (SPS) sensor of extracellular amino acids
Localization:
Intensity:
Fold change:
Significance:
-
C’ GFP library in SD
ER366.16 -
N' NOP1pr-GFP in SD
ER87.3053 -
N' TEF2pr-mCherry in SD

ER,vacuole100.796 -
N' NATIVEpr-GFP in SD
ER118.113 -
N' TEF2pr-VC and Cyto-VN in SD

ambigous35.737 -
C’ GFP library in SD+DTT
ER170.30.46Yes -
C’ GFP library in SD+H2O2

ER258.340.7No -
C’ GFP library in Starvation Media
vacuoleN/AN/AYes -
C’ GFP library on the background of Pup2-DaMP

ER -
C’ GFP library on the background of CCT mutant

ER392.931.07307No
